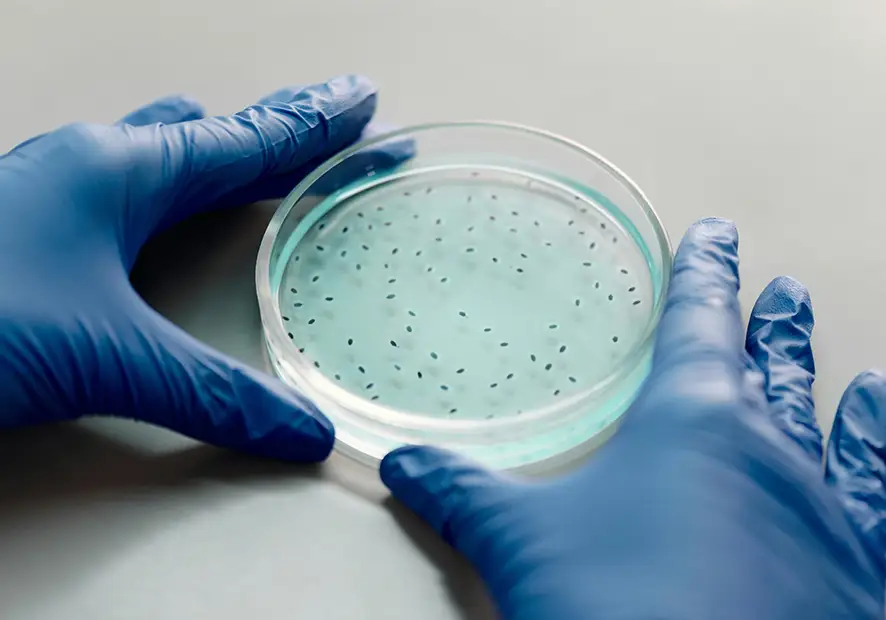

Parasites internes : êtes-vous à risque sans le savoir ? Symptômes et solutions.
Les parasites internes représentent un problème de santé publique majeur, touchant des millions de personnes dans le monde. Cet article vous propose un guide complet pour comprendre, Identifier et traiter les parasitoses interne chez L’Homme.
Les parasites intestinaux représentent un problème de santé publique majeur, touchant des millions de personnes dans le monde. Cet article vous propose un guide complet pour comprendre, Identifier et traiter les parasitoses interne chez L’Homme.
Qu’est-ce qu’une parasitose interne ?
Une parasitose interne est une infection causée par un parasite qui vit à l’intérieur du corps humain. Ces parasites peuvent être des protozoaires (organismes unicellulaires) ou des helminthes (vers).
Ils pénètrent dans l’organisme par différentes voies et se logent dans divers organes, comme les intestins, le foie, les poumons et même le cerveau. Ils se nourrissent des nutriments de leur hôte, provoquant une variété de symptômes et de complications.
Les causes des parasites internes
Les causes des parasites internes sont multiples et variées. Voici les principales voies de contamination :
- Consommation d’aliments ou d’eau contaminés: Les aliments crus ou mal cuits, les fruits et légumes non lavés, l’eau non potable peuvent contenir des œufs ou des larves de parasites.
- Mauvaise hygiène: Le manque d’hygiène, notamment le lavage des mains insuffisant, favorise la transmission des parasites.
- Contact avec des animaux infectés: Certains animaux domestiques, comme les chiens et les chats, peuvent être porteurs de parasites transmissibles à l’homme.
- Voyages dans des zones à risque: Les régions tropicales et subtropicales présentent un risque plus élevé de parasitoses.
- Système immunitaire affaibli: Les personnes ayant un système immunitaire affaibli sont plus susceptibles de contracter des infections parasitaires.
D’où proviennent les parasites internes ?
L’origine des parasites internes est diverse. Ils peuvent provenir :
- De l’environnement: sols contaminés, eau non potable, aliments crus ou mal cuits
- Des animaux: animaux domestiques ou sauvages porteurs de parasites transmissibles à l’homme
- D’autres personnes infectées: transmission directe ou indirecte (via des objets contaminés)
Les différents types de parasites internes
Il existe une grande variété de parasites internes pouvant infecter l’homme. Nous les regrouperons en 2 grandes catégories : les Protozoaires et les Helminthes.
Voici quelques exemples :
Protozoaires (organismes unicellulaires microscopiques)
- Giardia lamblia: responsable de la giardiase, une infection intestinale causant diarrhée, douleurs abdominales et fatigue.
- Entamoeba histolytica: responsable de l’amibiase, une infection pouvant toucher l’intestin, le foie et d’autres organes.
Helminthes (vers parasites pluricellulaires)
Il existe plusieurs cathégories d’helminthes : les nématodes (vers ronds) comme les oxyures ou les ascaris, les cestodes (vers plats segmentés) comme les ténias, les trématodes (douves) comme les schistosomes.
- Ascaris lumbricoides: responsable de l’ascaridiose, une infection intestinale pouvant causer des douleurs abdominales, des nausées et des vomissements.
- Trichuris trichiura: responsable de la trichocéphalose, une infection intestinale pouvant causer des douleurs abdominales, de la diarrhée et une anémie.
- Ankylostomes: responsables de l’ankylostomiase, une infection intestinale pouvant causer une anémie, des douleurs abdominales et une fatigue.
- Taenia saginata et Taenia solium: responsables du tæniasis, une infection intestinale causée par l’ingestion de viande de bœuf ou de porc contaminée.
- Echinococcus granulosus: responsable de l’échinococcose, une infection pouvant former des kystes dans le foie, les poumons et d’autres organes.
Les symptômes généraux des parasites internes
Les symptômes des parasites internes varient en fonction du type de parasite, de sa localisation et de l’intensité de l’infection.
Manifestations générales
- Fatigue, faiblesse
- Perte de poids inexpliquée
- Fièvre intermittente
- Anémie
Troubles digestifs
- Douleurs abdominales
- Nausées, vomissements
- Diarrhées ou constipation
- Ballonnements
- Perte d’appétit
- Amaigrissement
Signes cutanés
- Démangeaisons (prurit anal pour l’oxyurose)
- Eruptions cutanées
- Urticaire
Autres symptômes possibles
- Toux, difficultés respiratoires (parasites pulmonaires)
- Troubles neurologiques (maux de tête, convulsions)
- Hépatomégalie, splénomégalie
Il est important de noter que certaines parasitoses peuvent être asymptomatiques ou se manifester de façon atypique.
Cas de l’oxyurose
Qu’est-ce que l’oxyurose ?
L’oxyurose, causée par le parasite Enterobius vermicularis, est l’une des parasitoses intestinales les plus fréquentes, notamment chez les enfants. Les oxyures sont de petits vers blancs qui vivent dans le rectum, les femelles pondent leurs œufs autour de l’anus, provoquant des démangeaisons caractéristiques.
Mode de contamination
La transmission se fait principalement par :
- Auto–infestation : grattage et portage des œufs à la bouche
- Contamination de l’environnement (literie, vêtements, etc.)
Symptômes spécifiques
Les principaux signes de l’oxyurose sont :
- Prurit anal intense, surtout le soir et la nuit
- Troubles du sommeil, irritabilité
- Douleurs abdominales
- Parfois, vulvovaginite chez les petites filles
- Présence de vers dans les selles ou sur le linge de toilette
Traitements et solutions contre les parasites internes
Le traitement des parasites internes repose principalement sur l’utilisation de médicaments antiparasitaires, également appelés vermifuges ou antihelminthiques. Ces médicaments sont disponibles sous différentes formes : comprimés, suspension buvable, suppositoires.
Combantrin

Combantrin 125 mg en boîte de 6 comprimés vermifuge en boîte de 6 comprimés est un antiparasitaire efficace contre les oxyures et les ascaris. Sa formule à base de pyrantel offre un traitement vermifuge puissant et bien toléré pour les adultes et les enfants de plus de 12 kg. Avec une action rapide, il élimine efficacement les parasites tout en minimisant les effets secondaires, faisant de lui un allié précieux dans la lutte contre les infections parasitaires.
Combantrin 125mg/2,5mL suspension buvable 15 mL est un antiparasitaire efficace contre les vers intestinaux. Sa formule à base de pyrantel offre un traitement vermifuge puissant et bien toléré pour les adultes et les enfants de plus de 12 kg. Avec une posologie adaptée selon le type de parasite et une action rapide, il élimine efficacement les vers tout en minimisant les effets secondaires, faisant de lui un allié précieux dans la lutte contre les infections parasitaires.

Fluvermal

Fluvermal 100 mg en boîte de 6 comprimés est un antiparasitaire efficace contre divers vers intestinaux. Sa formule à base de flubendazole offre un traitement vermifuge puissant et bien toléré pour les adultes et les enfants de plus de 6 ans. Avec une posologie adaptée selon le type de parasite et une action rapide, il élimine efficacement les vers tout en minimisant les effets secondaires, faisant de lui un allié précieux dans la lutte contre les infections parasitaires.
Fluvermal 2% suspension buvable 30 mL avec cuillère-mesure de 5 mL est un antiparasitaire efficace contre divers vers intestinaux. Sa formule à base de flubendazole offre un traitement vermifuge puissant et bien toléré pour les adultes et les enfants de plus d’un an. Avec une posologie adaptée selon le type de parasite et une action rapide, il élimine efficacement les vers tout en minimisant les effets secondaires, faisant de lui un allié précieux dans la lutte contre les infections parasitaires

Important: Il est essentiel de consulter un médecin pour obtenir un diagnostic précis et un traitement adapté. Le médecin déterminera le type de parasite en cause et prescrira le médicament le plus approprié, en tenant compte de l’âge et de l’état de santé du patient.
Durée du traitement contre les parasites internes
La durée du traitement varie en fonction du type de parasite et du médicament utilisé. En général, une prise unique est suffisante pour les oxyuroses, mais il peut être nécessaire de renouveler le traitement après quelques semaines pour prévenir les réinfections. Pour les autres types de parasites, la durée du traitement peut varier de quelques jours à plusieurs semaines.
Mesures hygiéno-diététiques complémentaires
En complément du traitement médicamenteux, il est essentiel d’adopter certaines mesures pour prévenir la réinfestation et limiter la propagation :
Hygiène personnelle
- Lavage fréquent des mains, en particulier avant les repas et après être allé aux toilettes
- Brossage régulier des ongles
- Port de sous-vêtements propres chaque jour
- Douche quotidienne, notamment pour l’oxyurose
Hygiène domestique
- Lavage à 60°C du linge de lit, serviettes et vêtements
- Nettoyage et aspiration fréquents des surfaces
- Désinfection des sanitaires
Mesures alimentaires
- Bien laver fruits et légumes avant consommation
- Cuire suffisamment la viande et le poisson
- Éviter la consommation d’eau non potable
Traitement de l’entourage
Pour certaines parasitoses comme l’oxyurose, il est recommandé de traiter simultanément tous les membres du foyer pour éviter les réinfestations.
En conclusion, les parasitoses internes représentent un enjeu de santé publique important. Une bonne connaissance de leurs causes, symptômes et traitements permet une prise en charge efficace. N’hésitez pas à consulter un professionnel de santé au moindre doute, et pensez à avoir toujours un vermifuge dans votre armoire à pharmacie, particulièrement si vous avez des enfants ou si vous voyagez fréquemment.